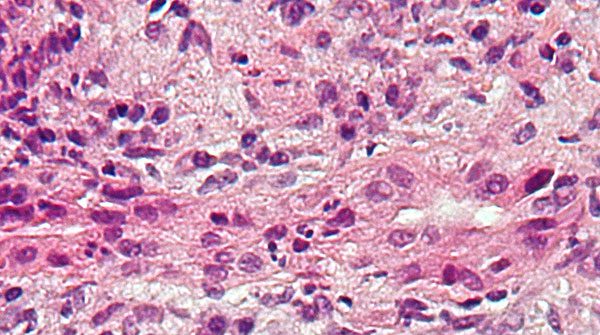
Indigenous patients with autoimmune liver disease face worse outcomes

Search for the cause and better treatments continues, researcher says
First Nations, Métis and Inuit people with primary biliary cholangitis – a debilitating autoimmune liver disease – have more advanced symptoms at diagnosis and worse long-term outcomes than others in Canada, according to research from a nationwide monitoring project.

Andrew Mason
“This autoimmune liver disease joins the collection of other autoimmune diseases with increased frequency and severity in Indigenous peoples, including multiple sclerosis, rheumatoid arthritis and systemic lupus erythematosus,” says co-lead author Andrew Mason, hepatologist and professor in the Faculty of Medicine & Dentistry.
“The cause for the increased severity of disease is not clear,” says Mason, who is the Western Canada project lead for the Canadian Network for Autoimmune Liver Disease, which pools data about patients with the relatively rare diseases of primary biliary cholangitis, autoimmune hepatitis and overlap syndrome.
Primary biliary cholangitis is a chronic illness in which the immune system misfires and attacks the bile ducts in the liver, slowly destroying them. It affects an estimated 318 people per million in Canada. According to the Canadian Liver Foundation, nine out of 10 patients are female. Early symptoms include fatigue and itchiness, with abdominal pain, swelling, jaundice and other symptoms developing later. There is no cure for the disease, although treatments can slow its progression. Some patients eventually experience liver failure and require a transplant.
 |
| Related Stories |
| Study shows promise for treating rare genetic liver disorder
|
| Manufacturing human organs … with farm animals
|
| A life-saving gift for our son-in-law
|
The researchers examined medical records for 1,538 patients from six cities across the country.
They found that Indigenous patients were more likely to have developed complications such as deteriorated liver function or liver cancer before diagnosis than new patients from other population groups, even though they were diagnosed at about the same age. Indigenous patients also had persistently poorer results on blood tests even after treatment.
Mason, who is also a member of the Li Ka Shing Institute of Virology, notes that primary biliary cholangitis can be hard to diagnose because it mimics other liver conditions. As with other autoimmune disorders, it appears that a combination of factors may lead to the disease, including an underlying genetic risk and environmental triggers such as infection or hormones.
“The link with worse disease in Indigenous populations may be related to an increased genetic risk compared with other Canadians,” Mason says.
Along with caring for patients with liver disease, Mason has devoted much of his research career to examining one of those potential environmental factors – a human betaretrovirus that is very similar to the mouse mammary tumour virus, known to cause cancer and linked with autoimmune biliary disease in mice. The human virus has been found in patients with breast cancer, lymphoma and primary biliary cholangitis, but no causal link has been confirmed. Mason recently wrote a book chapter and edited a special issue of the academic journal Viruses exploring the controversy surrounding the virus.
Mason says the next step for his own lab’s research is to refine a blood test they have developed to more easily detect the human betaretrovirus in patients. He reports that some primary biliary cholangitis patients get symptom and liver test improvement from long-term use of repurposed antiviral drugs originally developed for HIV/AIDS, particularly with the fatigue associated with the disease, indicating a possible viral link.
| By Gillian Rutherford
Gillian Rutherford is a reporter with the University of Alberta’s Folio online magazine. The University of Alberta is a Troy Media Editorial Content Provider Partner.
The opinions expressed by our columnists and contributors are theirs alone and do not inherently or expressly reflect the views of our publication.
© Troy Media
Troy Media is an editorial content provider to media outlets and its own hosted community news outlets across Canada.